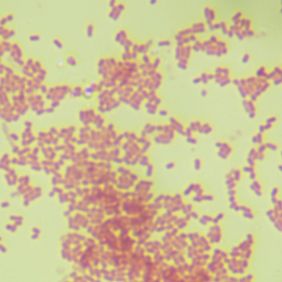
阪崎肠杆菌

搜索到 169 条记录
- 当前分类
- 子分类
- 品牌
南模生物
其它
ek-bioscience
atcc
chondrex
阿拉丁
agilent
bestbio贝博
信帆生物
卡文斯
维通利华(vital river)
sciencell
tissue solutions
杰克森实验室 the jackson laboratory
dyets
vitalstar
翌圣生物(yeasen)
富衡生物
medical discovery leader
research diets
tdb labs
yuanmu
probetex
sigma
烜雅生物
碧云天(beyotime)
abbexa
cyagen
duchefa
engreen
finnzymes
rd biosciences
sigma-aldrich
solarbio
umibio
兰博利德(lablead)
玉研仪器
诺唯赞(vazyme)

布病抗原检测卡
布病抗原检测卡 本试剂采用胶体金免疫层析试验(GICA)原理制成,样本加入到加样孔后与胶体金标记物一起沿层析膜移动,若样本中存在布病抗原则与胶体金标记物及检测线上的扑捉物结合而显示紫红色,若样本中不存在布病抗原则不产生颜色反应。 【样本准备】 按常规方法抽取2-3ml牛/羊血液置
品牌:德货号:50

纯化叶绿体DNA萃取试剂盒
供应试剂主要类别:细胞技术、分子技术、蛋白化学、免疫抗体、医学技术、生物化学、模式生物、微生物、植物、载体、毒理、营养、平台等等相关技术的各种大量试剂。 其中植物技术相关试剂类别如下: 植物细胞分析试剂专题 植物分子分析试剂专题 植物叶绿体分析试剂专题 植物酶学分析试剂专题 植物
货号:现GMS16011.1供应商:杰美基因

GV3101 Agrobacterium Strain
GV3101 Agrobacterium Strain STR3005 Packing 100ul Storage condition -80 鈩?/p GV3101 Agrobacterium Strain Genotype C58 (rif R) Ti pMP90 (pTi
文献支持品牌:LSM Bio货号:STR3005
¥1180

Research Diets D12450B 10 kal% 低脂饲料(对照饲料)
Research Diets D12450B 低脂饲料 货号:D12450B 脂肪含量:10kcal%、 应用:D12492 60 kcal%高脂饲料的对照饲料 D12450B 10 kcal% 低脂饲料可作为D12492 60 kcal%高脂饲料的对照饲料。两者具有相同的配方成份
品牌:Research Diets货号:D12450B

13C Spinach(Spinacia oleracea)菠菜
货号 英文名称 中文名称 13C Spinach(Spinacia oleracea)菠菜 U-63101 leaf/stem 叶/茎杆 U-63102 root 根 包装规格:0.1g,1g,5g,丰度:97% 上海赛弗生物科技有限公司 总代理 地址:上海市闵行区新骏环路245
品牌:Agrieco货号:各种规格

C57小鼠
1921年C.C.Little用Abby Lathrop近亲交配,育成数个近交系的时候,雌鼠57号与雄鼠52号交配为最初的交配对,所培育出的后代被标记为C57,因为毛色为固定的黑色,所以命名为C57BL。C57有很多亚系,其中C57BL/6常被认作“标准”近交系,是实验室中最常用
品牌:柏讴生物货号:TOP001
¥40

60 kca1%高脂及胆碱缺乏鼠粮
此产品为现货流动库存,库存数量、销售价格及相关信息有变动的,以实际库存、价格及相关信息确认为准,下单前请先咨询在线客服。 订购须知:1)所有产品仅可用于科研目的的生物学实验,严禁用于人体或动物的医疗目的;2)产品包装以实物为准,网页图片仅为公司部分产品实物包装,仅作参考;3)产品
品牌:Dyets货号:CD-HF60-5kg

绿色荧光转基因小鼠(GFP转基因小鼠)
GFP转基因小鼠 EGFPTg/+转基因小鼠: EGFP转基因小鼠的启动子为beta-Actin,表达方式为全身表达,可以直接在激发光下看到荧光,但在早期研究中也有指在毛发以及血液中无荧光。 EGFP基因构建在pCAGGS载体上,该载体具有鸡β-actin启动子、CMV增强子,
品牌:cyagen货号:Tg10003

Alzet渗透泵代理
重复给药的动作,解放实验人员的时间和精力 成本效益(靶向给药)与批间差异控制 使用相关: 《Alzet渗透泵科学选型指南》 《Alzet渗透泵里面有气泡怎么解决?》Alzet植入式胶囊渗透压泵,1003D/1007D1004/1002我们常备现货,欢迎详询!免费技术咨询,全程指导使
文献支持品牌:Alzet货号:1004.1002.1006等全部货号

PTS猪用旋毛虫病抗体快速检测卡(供屠宰场)
PTS猪用旋毛虫病抗体快速检测卡(供屠宰场) 预期用途 猪旋毛虫病毒快速检测卡采用胶体金免疫层析技术,用于检测猪血清、全血样品中的猪旋毛虫病毒抗体,可作为该病的辅助检测工具。 检测原理——猪蓝耳病毒抗体检测卡 如果待检样品中含有猪旋毛虫病毒抗体,则会与胶体金标记的抗猪第二抗体及检测
品牌:其他货号:JL2000

链格孢菌提取物Alternaria alternata
CITEQ Biologics专注于过敏原提取物的生产和销售。过敏原包括:尘螨、霉菌、昆虫等,这些过敏原有不同纯度级别和规格,广泛用于哮喘和过敏分析。
品牌:Citeq Biologics货号:09.01.85

人正常胃类器官培养基
2-3min,添加人正常胃类器官传代培养缓冲液终止消化,离心5min弃去混合液,添加适量人正常胃类器官传代培养缓冲液重悬移入1.5ml离心管,300g离心5min弃去液体进行第4步。 (4)类器官收集后,添加基质胶重悬,每孔25ul基质胶铺在24孔细胞培养板中,放置培养箱中10-1
品牌:爱必信(absin)货号: abs9736

植物可溶性糖含量测试盒
上海富雨生物科技有限公司部分生化试剂盒 产品名称 产品名称 辅酶ⅠNAD(H)含量测试盒 酰基转移酶(AAT)测试盒 NAD激酶(NADK)测试盒 丙,酮酸脱羧酶(PDC)测试盒 乳酸脱氢酶(LDH)测试盒 肝脂酶(HL)测试盒 NAD-苹果酸脱氢酶(NAD-MDH)测试盒 甘油
品牌:FUYUBIO货号:FY-YX0496SG

兔抗羊IgG血清
'-20℃ 保存,有效期2年 '-20℃ 保存,有效期2年 '-20℃ 保存,有效期2年 '-20℃ 保存,有效期2年 '-20℃ 保存,有效期2年 '-20℃ 保存,有效期2年 '-20℃ 保存,有效期2年 '-20℃ 保存,有效期2年 '-20℃ 保存,有效期2年
品牌:兰博利德(LABLEAD)货号:9033

HRP标记小鼠抗V5-Tag单克隆抗体
产品信息 产品名称 产品编号 规格 储存 价格(元) HRP-conjugated V5-Tag, Mouse mAb 小鼠抗V5-Tag单克隆抗体,HRP标记 30803ES60 100μl (200次) -20℃ 2527 产品描述 V5-Tag是一种合成的14aa多肽(G
品牌:翌圣生物(Yeasen)货号:30803ES60

昆明链霉菌/昆明链霉菌/DSMZ41684=ATCC35682
昆明链霉菌/昆明链霉菌/DSMZ41684=ATCC35682 菌种及培养条件的选择 菌种的选择对冻干的效果也是很重要的,乳酸菌因种属的不同其抗冻能力也互不相同。如链球菌属抗冻能力较强,明串珠菌和乳杆菌则稍差一些。细菌在稍低于最适生长温度中培养,收集的细胞耐冻能力较强;或通过优化
文献支持品牌:EK-Bioscience货号:A0989
阪崎肠杆菌
阪崎肠杆菌菌种简介: 菌种名称 阪崎肠杆菌 规格 冻干粉 生长条件 37℃;18-24h;好氧 菌种主要应用 研究;教学 阪崎肠杆菌大小:1-2mm 形状:圆形 边缘:整齐 透明度:不透明 颜色:浅黄色 隆起度:中间凸起 表面:明亮光滑 质地:湿润黏稠 保存条件:2-8℃ 安瓿管
品牌:YLKBIO货号:YLK-JZ0316

氢氧化铝佐剂Aluminum Hydroxide Gels(Alum) Adjuvant上海睿安生物13611631389
氢氧化铝佐剂Aluminum Hydroxide Gels(Alum) Adjuvant 博奥龙Biodragon货号KX0210054,有提供10ml、50ml两种规格包装 (铝离子含量:10mg/ml) 常温运输,4-8℃保存(切勿结冰),保质期18个月 博奥龙Biodrago
文献支持品牌:博奥龙Biodragon货号:KX0210054
¥1200.01















